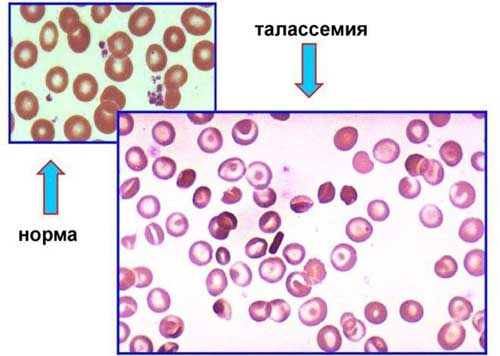

Причины талассемии
Заболевание изучено достаточно глубоко, так как оно является довольно распространенным. Известно, что первые изменения происходят при нарушении процесса синтеза белковых цепей гемоглобина, который отвечает за связывание молекул кислорода и их транспортировку ко всем клеткам организма.
Чаще всего заболевание развивается из-за генов, которые дети получают в наследство от родителей. В тех генах, которые отвечают за синтез гемоглобина, выявляются мутации.
При анализе структуры гемоглобина можно обнаружить пигмент, содержащий железо и две пары белковых соединений: альфа- и бета-цепи. Если синтез одной из этих цепей нарушается, то вторая начинает накапливаться.
Изменения вызываются генами, которые отвечают за образование белка гемоглобина. При наличии мутации происходит сбой в правильном наборе аминокислот в цепочке. Это явление также характерно для возбудителя малярии.
Наследственность у ребенка может проявляться в двух формах:
- Гомозиготная форма патологии – от обоих родителей одновременно.
- Гетерозиготная форма – от одного из родителей.
Талассемия — это наследственное заболевание крови, которое характеризуется нарушением синтеза гемоглобина. Врачи отмечают, что это заболевание чаще всего встречается у людей, происходящих из Средиземноморья, Ближнего Востока и Юго-Восточной Азии. Основной причиной талассемии является мутация в генах, отвечающих за производство альфа- или бета-цепей гемоглобина. В результате этого процесса у пациентов наблюдается анемия, усталость и другие симптомы, связанные с недостатком кислорода в организме.
Специалисты подчеркивают важность ранней диагностики и генетического консультирования для людей с семейной историей заболевания. Лечение может включать регулярные переливания крови и терапию железом, что позволяет значительно улучшить качество жизни пациентов. Врачи настоятельно рекомендуют проводить скрининг на талассемию в регионах с высокой распространенностью заболевания, чтобы предотвратить его развитие и обеспечить своевременную помощь.

Классификация
Если аномальный белок гемоглобина передается от обоих родителей, это приводит к тяжелой форме заболевания, известной как большая талассемия или болезнь Кули, названная в честь врача, который ее описал.
Данная форма наследуется по рецессивному типу (двухаллельная система) и связана со снижением синтеза полипептидных цепей. Если аномалия присутствует только от одного родителя, то при отсутствии крайне неблагоприятных условий симптомы могут не проявляться.
В современной медицине выделяют несколько форм этого заболевания:
- Альфа-талассемия. Она возникает при отсутствии одного или нескольких генов, которые в норме должны присутствовать по два от каждого родителя. Это количество необходимо для обеспечения достаточной выработки альфа-глобина. При отсутствии двух генов могут проявляться симптомы анемии. Если отсутствуют три гена, диагностируется гемоглобинопатия H, которая проявляется выраженными признаками малокровия. Отсутствие четырех генов – редкое явление, известное как «водянка плода». Такие дети могут не выжить до или сразу после рождения.
- Бета-талассемия возникает при нарушении одного или двух генов, которые должны быть по одному от каждого родителя. В этом случае наблюдается недостаточная выработка бета-глобина. Если изменен один ген, человек становится носителем болезни, и возможно проявление умеренной анемии. При изменении обоих генов одновременно ставится диагноз бета-талассемия интермедия (анемия Кули), при которой развивается тяжелый анемический синдром. Гомозиготная бета-форма проявляется к году жизни ребенка и имеет различные признаки. Гетерозиготная форма (малая талассемия) может проявляться размытыми симптомами или вовсе отсутствовать.
Важно отметить, что в некоторых случаях гомозиготная форма может протекать легко и не подлежит классификации как большая талассемия, поэтому ее обозначают как промежуточную.
Эта патология имеет три степени тяжести:
- Тяжелая. Аномальные изменения настолько выражены, что ребенок может не дожить до года.
- Среднетяжелая. Ребенок может прожить около восьми лет.
- Легкая форма. Взрослый человек может умереть, не дожив до пожилого возраста.
Несмотря на общий диагноз, β-талассемия может значительно различаться по результатам исследований, проявлениям, клиническому течению, методам лечения и прогнозам на будущее.
| Характеристика | Описание | Примечание |
|---|---|---|
| Название болезни | Талассемия | Генетическое заболевание крови |
| Тип заболевания | Наследственное | Передается от родителей к детям |
| Причина | Мутации в генах, ответственных за синтез белков глобина (α- или β-талассемия) | Мутации приводят к снижению или отсутствию синтеза одного из глобиновых цепей гемоглобина |
| Тип наследования | Аутосомно-рецессивное | Для проявления заболевания необходимы две мутантные копии гена (по одной от каждого родителя) |
| Симптомы | Анемия (бледность, слабость, утомляемость), задержка роста, желтуха, увеличение селезенки и печени, деформация костей | Тяжесть симптомов зависит от типа и тяжести талассемии |
| Диагностика | Анализ крови (полный анализ крови, электрофорез гемоглобина) | Генетическое тестирование для подтверждения диагноза и определения типа талассемии |
| Лечение | Регулярные переливания крови, хелатотерапия (удаление избытка железа), трансплантация костного мозга | В некоторых случаях возможно лечение с помощью лекарственных препаратов |
| Профилактика | Генетическое консультирование для пар с семейным анамнезом талассемии | Пренатальная диагностика (для выявления талассемии у плода) |
Симптомы и проявления
Признаки заболевания зависят от типа и времени возникновения мутации. Большая талассемия проявляется при гомозиготном состоянии и становится заметной у новорожденных:
- Увеличенная в высоту черепная коробка.
- Верхняя челюсть значительно больше нижней.
- Лицевой скелет напоминает монголоидный тип.
К первому году жизни можно наблюдать следующие симптомы:
- Увеличение перегородки носа и ее приплюснутая форма.
- Появление аномальных костных образований в области стоп.
- Проблемы с прикусом.
- Желтушность кожи из-за нарушенной работы селезенки.
Недостаток кислорода в тканях приводит к следующим проявлениям:
- Увеличение печени и развитие раннего цирроза.
- Сердечная недостаточность, вызванная накоплением избыточного железа в миокарде, что нарушает его сократимость.
- Замедление физического и умственного развития.
- Развитие сахарного диабета.
У взрослых пациентов наблюдаются следующие симптомы:
- Язвы на коже, возникающие из-за нарушений в кровообращении.
- Частые случаи пневмонии.
- Регулярные переломы костей.
- Воспалительные процессы в желчном пузыре, связанные с образованием камней.
- Кардиосклероз — заболевание сердца, при котором происходит разрастание соединительной ткани в миокарде, замещение мышечных волокон и деформация клапанов.
- Развитие сепсиса при инфекционных заболеваниях.
- Половые расстройства.
При промежуточной форме заболевания внешние изменения отсутствуют, умственное и физическое развитие остаются в пределах нормы, однако наблюдается увеличение селезенки и хрупкость костей.
Талассемия — это наследственное заболевание крови, которое затрагивает выработку гемоглобина, белка, отвечающего за транспортировку кислорода в организме. Люди, страдающие от этой болезни, могут испытывать анемию, усталость и другие симптомы, связанные с недостатком кислорода. Талассемия делится на две основные формы: альфа и бета, в зависимости от того, какая часть гемоглобина нарушена.
Причиной заболевания является мутация в генах, отвечающих за синтез гемоглобина, что приводит к его недостатку или аномалиям. Это состояние чаще встречается у людей, происходящих из Средиземноморья, Ближнего Востока и Южной Азии. Важно отметить, что талассемия передается по наследству, и риск ее развития увеличивается, если оба родителя являются носителями гена. Лечение может включать регулярные переливания крови и терапию железом, что помогает контролировать симптомы и улучшать качество жизни пациентов.

Признаки большой талассемии
Наблюдаются сразу после рождения:
- Удлиненная форма головы.
- Лицо с монголоидными чертами.
- Увеличенная верхняя челюсть.
- Увеличенная носовая перегородка.
Анализ крови показывает наличие гепатомегалии, что может привести к развитию цирроза и диабета.
Если при рождении диагностируется “талассемия” с выраженными симптомами, то такие дети, как правило, могут прожить около года.
Симптомы малой талассемии
Когда генная мутация наследуется от одного из родителей, возникает малая талассемия. В этом случае симптомы могут быть нечеткими или вовсе отсутствовать. Клинические проявления включают:
- Увеличенную утомляемость.
- Сниженную работоспособность.
- Частые головные боли и внезапные головокружения.
- Бледность кожи с желтоватым оттенком.
- Увеличение селезенки.
Наибольшую угрозу представляет собой риск повышения восприимчивости к инфекциям.

Диагностика заболевания
Обследование состоит из нескольких ключевых этапов:
- Сбор анамнеза. На этом этапе выявляются опасные заболевания, которые могли быть диагностированы у женщины во время беременности и способствовать возникновению патологии.
- Оценка течения беременности.
- Подробный осмотр врачом: анализируется общее состояние пациентки, состояние и цвет кожи, а также проводится пальпация брюшной области для выявления гепатоспленомегалии.
- Опрос родителей или самого пациента для определения степени выраженности симптомов и тяжести заболевания.
Кроме того, назначаются следующие лабораторные исследования:
- Биохимический анализ крови.
- ПЦР-тесты.
- Исследование биосинтеза гемоглобиновых цепочек.
- Общий анализ крови.
- Электрофорез гемоглобина.
Также требуется применение инструментальных методов диагностики:
- УЗИ брюшной полости (для выявления увеличенной селезенки).
- Рентгенография костей.
- Пункция костного мозга.
- Оценка развития плода в утробе матери.
В случае выявления гомозиготной формы патологии рекомендуется искусственное прерывание беременности.
Лечение
После определения природы заболевания и его симптомов, следует выбрать подходящие методы лечения. Основное внимание в терапевтических мероприятиях уделяется восстановлению нормального уровня гемоглобина.
Среди других методов терапии можно выделить:
- В случаях тяжелых форм заболевания требуется регулярное переливание крови, хотя этот метод обеспечивает лишь временное облегчение.
- Применение хелатов железа.
- В современной медицине доступно переливание размороженных или отфильтрованных эритроцитов, что является более безопасным вариантом для детей.
- При увеличении селезенки может потребоваться ее удаление. Хирургическое вмешательство возможно только после достижения ребенком пятилетнего возраста, так как это связано с повышенным риском инфекционных осложнений.
- Трансплантация костного мозга, однако поиск подходящего донора может быть затруднительным.
К клиническим рекомендациям также относится специальная диета, которая включает в себя орехи, чай, сою и какао — продукты, препятствующие усвоению железа. Рекомендуется также употребление аскорбиновой кислоты, способствующей выведению железа из организма.
Возможные осложнения
При наличии умеренных и тяжелых форм заболевания лечебные мероприятия сосредоточены на увеличении продолжительности жизни и предотвращении возможных осложнений, таких как:
- Заболевания сердца и печени. Повышенное содержание железа в организме может привести к повреждению различных тканей, особенно страдают сердечная мышца и печень. Это часто становится причиной летального исхода, поэтому важно регулярно проводить переливание крови.
- Инфекционные процессы в организме также могут привести к смерти пациента, особенно у тех, кто перенес операцию по удалению селезенки.
- Остеопороз. При этом заболевании костные структуры становятся более хрупкими и подвержены частым переломам.
Профилактика
Талассемия не поддается лечению, поэтому важно предпринимать профилактические меры, которые включают в себя:
- Проведение диагностики в период беременности, особенно если у обоих родителей имеется талассемия.
- Выполнение генетического тестирования.
- При необходимости осуществление искусственного прерывания беременности.
Прогнозы
При выявлении малой талассемии прогнозы благоприятные, и человек может вести полноценную жизнь, продолжительность которой практически не отличается от жизни здорового человека.
Что касается бета-талассемии, то лишь небольшая часть пациентов достигает взрослого возраста.
Тяжелая гомозиготная форма заболевания требует регулярного лечения, так как только такие процедуры, как переливание крови, способны поддерживать жизнь пациента.
Вопрос-ответ
От чего появляется талассемия?
Талассемия – генетически детерминированное заболевание. Она проявляется клинически только в случае, когда носителями дефектного гена являются оба родителя.
Можно ли вылечить талассемии?
Болезнь талассемия не излечивается до конца, поэтому суть лечения заключается в нормализации уровня гемоглобина в крови. При тяжелых формах заболевания больному необходимо постоянное переливание очищенных эритроцитов. Также нужно выводить из организма избыток железа с помощью препаратов группы хелатов.
Советы
СОВЕТ №1
Изучите семейную историю. Если у вас или ваших близких есть случаи талассемии, важно знать о рисках и возможностях генетического тестирования. Это поможет вам лучше понять, как болезнь может повлиять на ваше здоровье и здоровье будущих поколений.
СОВЕТ №2
Регулярно проходите медицинские обследования. Люди с талассемией могут испытывать различные симптомы, такие как усталость и анемия. Регулярные анализы крови помогут контролировать уровень гемоглобина и выявить возможные осложнения на ранней стадии.
СОВЕТ №3
Обратите внимание на питание. Правильное питание может помочь поддерживать здоровье и уровень энергии. Включайте в рацион продукты, богатые железом и витаминами, такими как фолиевая кислота, чтобы поддерживать кроветворение.
СОВЕТ №4
Обратитесь к специалистам. Если у вас есть подозрения на талассемию или вы уже получили диагноз, важно работать с гематологом и другими медицинскими специалистами для разработки индивидуального плана лечения и управления заболеванием.